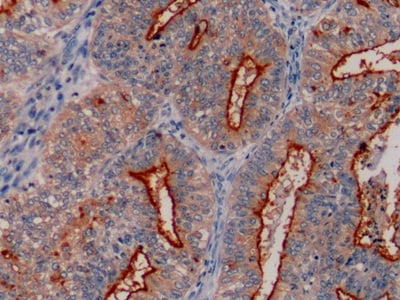
product-image-AAA130832_IHC11.jpg

Rabbit MUC1 Monoclonal Antibody | anti-MUC1 antibody
MUC1 (RBT-MUC1)
Synonyms
MUC1, Antibody; MUC1 (RBT-MUC1); CD227; MUC1; mucin 1 cell surface associated; sc7313; sc-7313; 7313; anti-Mucin 1; anti Mucin 1; anti-MUC1; anti MUC1; anti-CD227; anti CD227; anti-mucin 1 cell surface associated; anti mucin 1 cell surface associated; Breast carcinoma associated antigen DF3; Carcinoma associated mucin; DF3 antigen; EMA; Episialin; H23 antigen; H23AG; MAM6; MUC 1; MUC 1 SEC; MUC 1 X; MUC1 alpha; MUC1 beta; MUC1 CT; MUC1 NT; MUC1 ZD; mucin 1 transmembrane; mucin 1; Mucin 1 subunit alpha; Mucin 1 subunit beta; peanut reactive urinary mucin; PEM; PEMT; polymorphic epithelial mucin; PUM; tumor associated epithelial mucin; tumor associated epithelial membrane antigen; tumor associated mucin; KL 6; Krebs von den Lungen 6; muc-1; anti-muc-1; anti muc-1; anti-MUC1 antibody
Host
Rabbit
Clonality
Monoclonal
Isotype
IgG
Form/Format
MUC1 is a rabbit monoclonal antibody derived from cell culture supernatant that is concentrated, dialyzed, filter sterilized and diluted in buffer pH 7.5, containing BSA and sodium azide as a preservative.
Control
Breast, Colon, Kidney, Fallopian Tube, Tonsil, Colon Adenocarcinoma
Localization
Nuclear
Related Product Information for anti-MUC1 antibody
Mucin 1, also known as MUC1, is a member of the mucin family and encodes a membrane-bound, glycosylated phosphoprotein. The protein is anchored to the apical surface of many epithelia by a transmembrane domain, the degree of glycosylation varying with cell type. Mucins are high molecular-weight glycoproteins which constitute the major component of the mucus layer that protects the gastric epithelium from chemical and mechanical aggressions. The MUC1 protein serves a protective function by binding to pathogens and also functions in a cell-signaling capacity. Overexpression, aberrant intracellular localization, and changes in glycosylation of this protein have been associated with carcinomas. Multiple alternatively-spliced transcript variants that encode different isoforms of this gene have been reported, but the full-length nature of only some has been determined.
MUC1 is a large cell, surface-mucin glycoprotein expressed by most glandular and ductal epithelial cells and some hematopoietic cell lineages. It is expressed on most secretory epithelium, including mammary gland and some hematopoietic cells. MUC1 antibody expression is seen in lactating mammary glands and overexpressed in more than 90% Breast Carcinomas and metastases. Transgenic MUC1 has been shown to associate with all four cebB receptors and localize with erbB1 (EGFR) in lactating glands.
MUC1 is a large cell, surface-mucin glycoprotein expressed by most glandular and ductal epithelial cells and some hematopoietic cell lineages. It is expressed on most secretory epithelium, including mammary gland and some hematopoietic cells. MUC1 antibody expression is seen in lactating mammary glands and overexpressed in more than 90% Breast Carcinomas and metastases. Transgenic MUC1 has been shown to associate with all four cebB receptors and localize with erbB1 (EGFR) in lactating glands.
Customer Reviews
Loading reviews...
Share Your Experience
Similar Products
Product Notes
The MUC1 (Catalog #AAA59447) is an Antibody produced from Rabbit and is intended for research purposes only. The product is available for immediate purchase. It is sometimes possible for the material contained within the vial of "MUC1, Monoclonal Antibody" to become dispersed throughout the inside of the vial, particularly around the seal of said vial, during shipment and storage. We always suggest centrifuging these vials to consolidate all of the liquid away from the lid and to the bottom of the vial prior to opening. Please be advised that certain products may require dry ice for shipping and that, if this is the case, an additional dry ice fee may also be required.Precautions
All products in the AAA Biotech catalog are strictly for research-use only, and are absolutely not suitable for use in any sort of medical, therapeutic, prophylactic, in-vivo, or diagnostic capacity. By purchasing a product from AAA Biotech, you are explicitly certifying that said products will be properly tested and used in line with industry standard. AAA Biotech and its authorized distribution partners reserve the right to refuse to fulfill any order if we have any indication that a purchaser may be intending to use a product outside of our accepted criteria.Disclaimer
Though we do strive to guarantee the information represented in this datasheet, AAA Biotech cannot be held responsible for any oversights or imprecisions. AAA Biotech reserves the right to adjust any aspect of this datasheet at any time and without notice. It is the responsibility of the customer to inform AAA Biotech of any product performance issues observed or experienced within 30 days of receipt of said product. To see additional details on this or any of our other policies, please see our Terms & Conditions page.Item has been added to Shopping Cart
If you are ready to order, navigate to Shopping Cart and get ready to checkout.